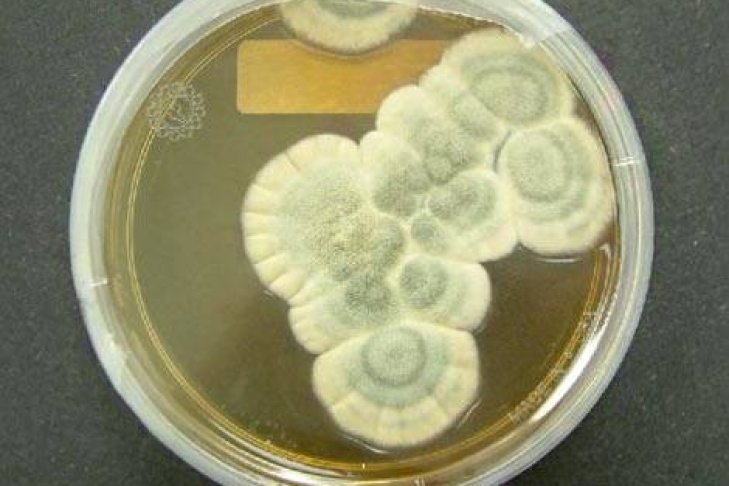

Историческую плесень в банке продали на аукционе за $15 тысяч
Британский аукционный дом Bonhams продал 90-летний образец засохшей плесени из лаборатории шотландского бактериолога Александра Флеминга - изобретателя первого антибиотика. Об этом сообщает "Страна".
Покупатель отдал за лот 11 875 фунтов стерлингов (около 15 тысяч долларов), сообщается на сайте аукциона. Согласно описанию, плесень находится в стеклянной банке. На ее дне лежит записка самого Флеминга, гласящая, что "из этой плесени был впервые получен пенициллин". Покупатель пожелал остаться неизвестным.
Первооткрыватель пенициллина сделал несколько десятков подобных баночек с куском плесени.
Он отправлял их в подарок ученым, а также общественным и политическим деятелям. Такие образцы были у папы Римского Пия XII, британского премьера Уинстона Черчилля и немецкой актрисы Марлен Дитрих.





 Политика «Федоров сказав, що потрібно Україні, щоб добити Росію»
Политика «Федоров сказав, що потрібно Україні, щоб добити Росію»  Происшествия «Свавілля у ТЦК: У Миколаєві 18 діб тримали чоловіка, щоб у нього зрослися ребра – Лубінець»
Происшествия «Свавілля у ТЦК: У Миколаєві 18 діб тримали чоловіка, щоб у нього зрослися ребра – Лубінець»  Политика «Навроцький назвав Україну державою, "яка вшановує геноцидників"»
Политика «Навроцький назвав Україну державою, "яка вшановує геноцидників"»  Общество «Глава оборонного відомства заявив про "тисячі" охочих підписати нові військові контракти»
Общество «Глава оборонного відомства заявив про "тисячі" охочих підписати нові військові контракти»  Происшествия «Вибух в Монако: Дружина українського бізнесмена зазнала ампутації ніг»
Происшествия «Вибух в Монако: Дружина українського бізнесмена зазнала ампутації ніг»  Мир «Россияне стали чаще спрашивать о конце войны, – ISW»
Мир «Россияне стали чаще спрашивать о конце войны, – ISW»